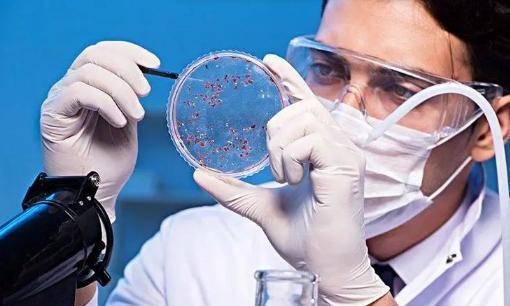

[太阳]2016年,美国一男子被查出癌症晚期,寿命仅剩3个月。没想到3个月后,癌细胞竟然消失了,而他的治疗方式让医生大呼神奇。 (信息来源:澎湃新闻——美国男子被告知“活不过三个月”,竟然靠吃狗药治好了?) 2016 年,美国俄克拉荷马州,50 岁的广告商乔・蒂彭斯还在为工作奔波,谁也没想到,一张常规体检的诊断书,瞬间把他的人生掀了个底朝天——他被查出小细胞肺癌晚期。 接诊医生仔细研究了他的病情后,说出的话像一把重锤砸在乔心上:“最多只剩 3 个月时间了。就算做化疗,效果也说不准,你现在的身体,恐怕扛不住化疗的副作用。” 这话一出口,乔懵了,绝望像潮水一样把他裹住。刚得知消息那几天,乔整个人都蔫了,提不起一点精神。可看着家人担忧的眼神,他又不甘心就这么放弃。 他开始疯狂查资料,不管是医学论文还是患者论坛,只要跟癌症治疗沾边的,他都不放过,就想在绝境里扒拉出一点希望。 在他快撑不下去的时候,一位兽医朋友给了他个消息,听起来有点离谱,却让他眼睛一亮:动物保健领域有个科学家发现,给狗狗治寄生虫的药,竟能抑制小白鼠体内的肿瘤生长。更神的是这位科学家自己之前也得了癌症,吃了这药后,癌细胞居然不见了! 乔心里又燃起了火苗。他当然知道,那个药是给动物用的驱虫药,从来没听说过能给人治癌症,也没有哪个正经医学机构说这药对人有用。可眼下医生都判了“死刑”,这说不定就是最后一根救命稻草。思来想去,他决定赌一把。 乔从宠物用品店买到了药,这药便宜得让人不敢相信,一片还不到 1 美元。结合自己查的资料和兽医朋友的建议,他给自己定了个“土办法”:每周吃 3 天“狗药”,再搭配上维生素等,他觉得这些东西说不定能跟药互相配合,让抑制癌细胞的效果更好。 吃药期间,乔没跟医生断了联系,经常跟主治医生说自己的身体情况。医生每次都劝他,这么自己吃药太冒险,没有科学依据,可乔只是听着,没停下。对他来说,这是当时唯一能抓住的希望。 日子就在又怕又盼的心情里一天天过,转眼到了2017 年 5 月,正好是医生说的“最后期限”。 乔揣着忐忑的心情去医院复查,当检查结果出来时,乔不敢信,见多识广的主治医生也瞪大眼睛:报告上写着乔体内的癌细胞没了,转移的那些肿瘤也不见了,身体状况在慢慢变好。 为了确认没搞错,医生又安排了好几次复查,结果都一样——这个被断定只剩 3 个月的晚期癌症患者,靠吃狗用驱虫药,竟然把癌细胞 “赶跑” 了! 之后,乔还在坚持吃狗用驱虫药,还主动加入了医学观察项目。到 2017 年 9 月,他的癌症没再复发,身体也越来越稳,基本能像以前一样正常生活了。 乔的事儿很快就通过网络和媒体传开了,有人为乔的好运气高兴,觉得这给那些走投无路的晚期患者带来了点安慰,也让大家看到别的可能;也有人开始开始关注 “老药新用”。 面对这么多关注,乔倒挺冷静,接受采访时总说,自己就是分享个人经历,可没说狗用驱虫药能治所有癌症。每个人的身体和病情都不一样,他能好可能只是个例,可别盲目学他。 而医学界的专家们则更谨慎,他们说乔能康复,可能是好几件事凑到一起的结果,除了芬苯达唑,他自己的免疫力、心态,还有搭配吃的那些东西,说不定都帮了忙。 专家们还提醒,虽然在小白鼠身上看到狗用驱虫药能抑制肿瘤,但人和动物不一样,现在还没有足够多、足够严格的人体试验证明这药对人治癌症有效又安全,要是盲目吃,耽误了正规治疗,或者吃出别的毛病,那就麻烦了。 这场从绝望里拼出来的 “生命逆袭”,不光改变了乔一个人的命运,还让全世界都开始思考癌症治疗、医学研究方向,还有医疗资源该怎么分配这些事情。 乔的经历告诉我们,碰到绝症,不放弃的劲儿很重要,但也得保持科学、理性,不能瞎来。而且这事儿也给医学界提了个醒,说不定 “老药新用” 里藏着新机会。 或许将来,经过科学改造,狗用驱虫药这类原本给动物用的药,真能帮人抗癌。但在那之前,顺着医学规律来,听医生的专业建议,才是癌症患者最稳妥的选择。